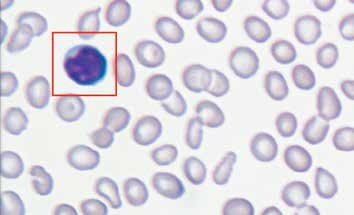

Vision Hema® Research Решение для исследовательской работы
Специализированный сканер-анализатор
Решение для исследовательской работы
- • Автоматическое сканирование образцов
- • Идентификация и преклассификация клеток крови
- • Быстрая верификация результатов
- • Анализ сложных и патологических клеток
- • Морфологический анализ
- • Расширенная статистика
- • Работа с изображениями. Подготовка виртуальных препаратов
- • Подготовка отчетов
- • Сканирование серии слайдов без постоянного присутствия оператора
- • Кассетная загрузка слайдов
- • Интернет и сетевые возможности


Cтандартизация и оптимизация исследовательской работы
Исследовательская работа требует особых подходов и особых инструментов. Vision Hema® Research специально разработана для успешного решения исследовательских задач.
• Верификация лейкоцитов, эритроцитов и тромбоцитов
• Автоматическое сканирование
• Анализ сложных и патологических клеток
• Идентификация и преклассификация клеток крови
Области применения
— Клинические исследования
— Лабораторные исследования
— Научные исследования
— Фармакология
— Образование
— Исследования клеток крови животных
Автоматическое сканирование

Vision Hema® сканирует микроскопический препарат и собирает данные для анализа, сортирует форменные элементы крови, и записывает результаты в базу данных.
Верификация лейкоцитов, эритроцитов и тромбоцитов

Специалист освобожден от рутинной монотонной работы. Готовые результаты анализа представлены в виде галерей клеток по группам. Вам остается только просмотреть результаты анализа и провести верификацию.
Анализ сложных и патологических клеток

Преклассификация по типам лейкоцитов с идентификацией незрелых и атипичных форм типов клеток крови, включая бласты; преклассификация нормобластов и других клеток не лейкоцитарного ряда.
Идентификация и преклассификация клеток крови

Cотрудник лаборатории выполняет верификацию результатов анализа, при необходимости проводит коррекцию и утверждает результаты анализа.
Достоверность и объективность, подтвержденные документально


Морфологический анализ
Классифицируйте объекты анализа по необходимым критериям.
Выбирайте необходимое количество групп и определяйте для каждой из групп свой диапазон измерения.
Часто используемые методики можно сохранять для простоты доступа к ним при проведении будущих
исследований.
Результаты и интерпретация анализа
Итоговые результаты
1. Количественные показатели
2. Лейкоцитарная формула
3. Эритроидный ряд
4. Кривая Прайс — Джонса
5. Эритроциты с включениями
6. Эритроцитометрия
7. Классификация эритроцитов по размеру
8. Классификация эритроцитов по цвету
9. Классификация эритроцитов по форме
10. Тромбоциты
Интерпретация результата
Заключение для отчета по результатам выполненных исследований и рекомендации по дальнейшему обследованию.
Работа с изображением

Эргономичные элементы управления позволяют быстро настроить изображение микроскопического препарата. Выделяйте важную часть изображения и сохраняйте ее как отдельный цифровой препарат. Для более удобной работы с микроскопическим препаратом его можно повернуть на определенный угол. Для получения качественного цифрового препарата используйте инструменты для работы с цветом: яркость, контрастность, насыщенность.
Подготовка виртуальных препаратов
Цифровой препарат незаменим в тех случаях, когда объект не попадает целиком в поле зрения на соответствующем увеличении микроскопа — его просто невозможно увидеть целиком без создания «виртуального» препарата.
Функция «Показать на слайде»
позволит найти нужное поле зрения при повторной микроскопии.
Подтвержденные результаты — ключ к достижениям
Расширенная статистика




Получайте статистическую информацию по определенному типу клетки и добавляйте ее в отчет исследования.
Система выполнит измерения и выведет результаты в наглядной форме — в виде гистограммы и разбивки галереи на соответствующие группы. Мониторинг и оценка образцов до и после эксперимента стали проще.
Подготовка отчета



Vision Hema® предлагает бланки отчетов на различные случаи — от простого анализа на треть страницы до подробного заключения о проведенном исследовании. Используйте стандартную форму отчета, или сами составляйте его так, как вам необходимо. Вы сами принимаете решение о том, каким будет ваш отчет.
Обучение и повышение квалификации


При работе с системой Vision Hema®, специалисты и лаборанты повышают свой опыт и квалификацию каждый день благодаря ведению атласа, просмотру изображений клеток крови и комментариев в динамике, а также обсуждая результаты анализа с коллегами и экспертами.
Сетевые возможности


Делитесь данными с коллегами. Получайте удаленные консультации и мнения экспертов. Проводите удаленный контроль и мониторинг вашего исследования. Отправляйте отчеты по электронной почте. Проводите видеоконференции с коллегами из разных городов и стран. Публикуйте работы в специализированных сетях Интернет.
Анализ клеток крови животных


Cбор клеток крови животных — мыши, кролики, собаки, кошки (анализ других видов животных по запросу).
Проведение научных исследований и простых анализов крови.